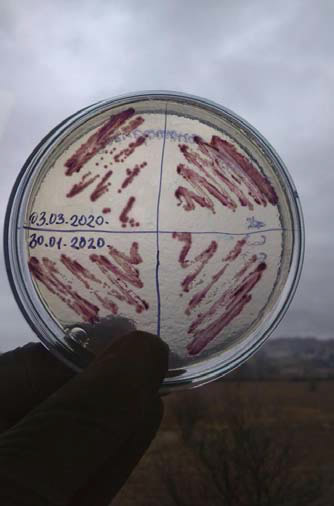

Upoznati tržište rada u Bosni i Hercegovini te steći radno iskustvo - cilj je programa STEP (Student Training and Empowerment Program) kojeg implementira Američko vijeće za međunarodno obrazovanje a finansijski podržava Ambasada Sjedinjenih Američkih Država.
Tokom obuke i prakse 24 mlade osobe iz Sarajeva i Banja Luke učili su kako se prilagoditi zahtjevima tržišta rada i prepoznati svoje prednosti, ali i slabosti. Medina Rondić, studentica Prirodno-matematičkog fakulteta u Sarajevu, bila je na praksi u Laboratoriji za vode Agencije za vodno područje rijeke Save, jedinoj bh. instituciji koja je učestvovala u projektu.

- S obzirom na to da je polje mog interesiranja mikrobiologija, najviše vremena provela sam radeći na mikrobiološkim analizama vode. Obnavljala sam neka od znanja stečenih na fakultetu, ali i ovladavala novim vještinama - ističe Medina. Ona dodaje da će iskustvo koje je stekla, zahvaljujući prije svega mentoricama Almi Hadžiahmetović i Aleni Šljuka, značajno doprinijeti razvoju njenih vještina, motivaciji za rad i napretku.

U toku obuke provedene su praktično sve faze pripreme mikrobioloških podloga, pojašnjava rukovoditeljica Sektora laboratorije za vode Nezafeta Sejdić. Ističe da je Medina radila na pripremi uzoraka za sve biološke parametre kvaliteta voda. - Nadamo se da će ovakvi programi biti nastavljeni na zadovoljstvo mladih i poslodavaca - dodaje Sejdić.
Program STEP ujedno je i doprinos borbi protiv problema velikog broja odlazaka mladih ljudi iz Bosne i Hercegovine. Čak 21% učesnika nastavilo je raditi kod poslodavca.
-Želim ohrabriti sve vas da vrijedno radite, ostanete u BiH i doprinesete vašoj zemlji u budućnosti. Svijetla budućnost BiH zavisi od ljudi poput vas-poručila je studentima direktorica Ureda za odnose sa javnošću Američke ambasade Allyson Algeo na ceremoniji održanoj povodom završetka programa STEP.
